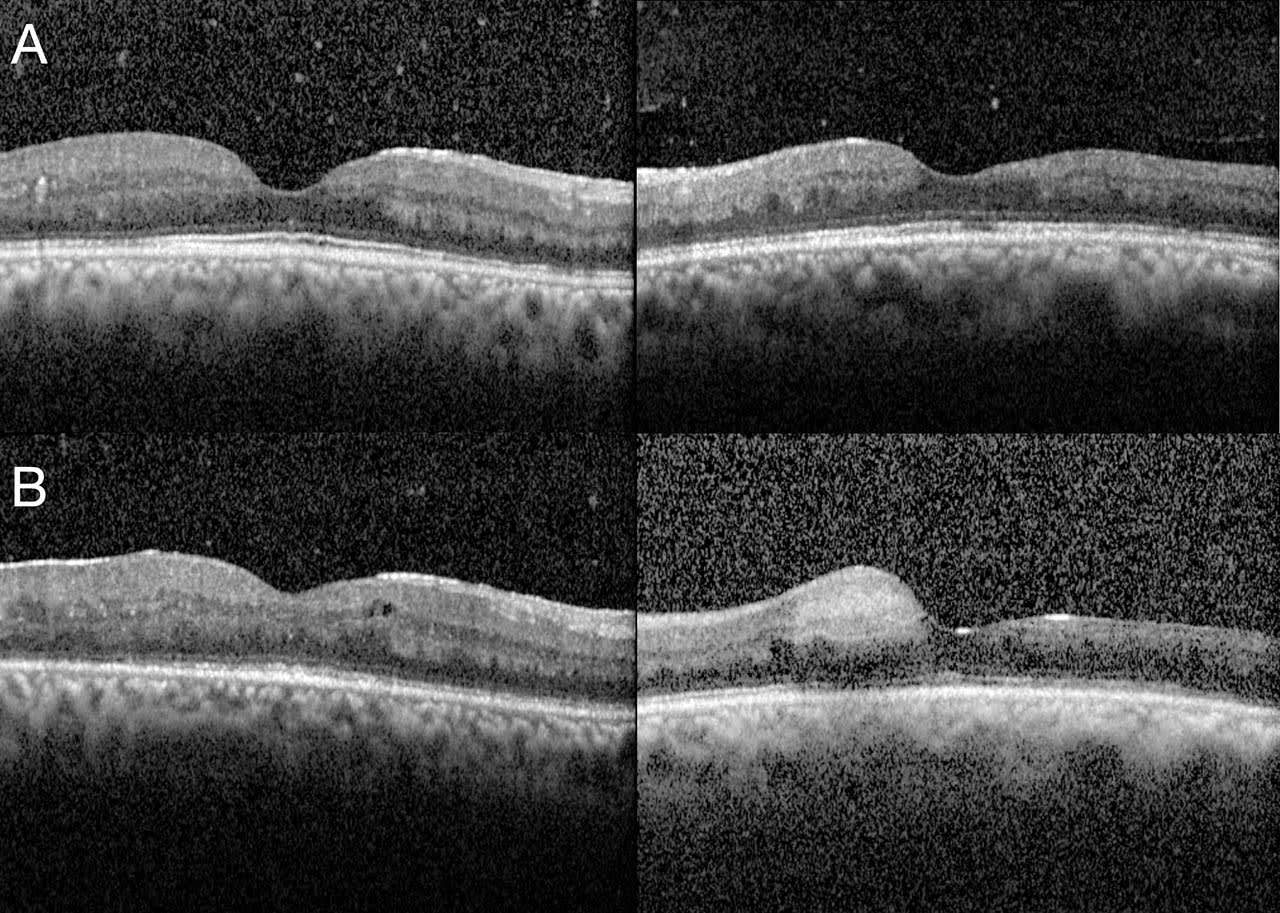

Loss of vision from a suspected retinal vascular disease could present with a variety of etiologies. It is important to keep options open during the diagnostic decision-making process to avoid premature and incorrect conclusions. Many patients who come to the eye clinic will have confounding and overlapping risk factors for retinal vascular disease due to common diseases like hypertension and diabetes.
Hypertension was a primary or contributing cause of death for 691,095 individuals in 2021, the most recent year for which data is available.1 The Centers for Disease Control (CDC) estimates that 48.1% of the US adult population has hypertension, and 22.5% have the condition under adequate control.2 Hypertension is a potent risk factor for retinal vein occlusion (RVO).3-5 In 1 study, hypertension was identified as a main contributing association for 48% of RVOs.6
Additionally, 14.7% of all US adults have diabetes, 8.5 million of whom met laboratory criteria for the diagnosis of Type 2 but were unaware of the diagnosis.7 Approximately 26.4% of those with diabetes in the US suffered from diabetic retinopathy in 2021, 1.84 million of whom were estimated to have vision-threatening manifestations.8
Therefore, it is tempting to assert with a high pretest probability that most patients who present at clinic with an apparent retinal vascular disease could have a vascular disorder whose antecedent is likely one of these more common preconditions. In this piece, we will explore an important masquerade that may have devastating results if not detected early through a case presentation.
Case
The patient is a 42-year-old African-American male who developed bilateral asymmetric vision loss over the course of 2 weeks prior to seeking medical care from an ophthalmologist. He had noted decreased acuity more in the left than the right eye, and reported new floaters and overall feeling of haze in both eyes. He had a history of hypertension, hyperlipidemia, and obesity with a previous body mass index (BMI) of 40 kg/m2, but he lost weight with the assistance of diet modification and a gastric sleeve. At the time of presentation, his BMI was 30 kg/m2. His blood pressure has been well controlled over the last 3 years. His most recent blood pressure was 125/82 which is improved since weight loss and is being assisted with amlodipine, hydrochlorothiazide, and metoprolol.
In his first visit with the ophthalmologist, the patient’s measured visual acuity was 20/20 OD and 20/30 OS. Eye pressure was normal, as was the anterior segment of both eyes. The ophthalmologist noted retinal vascular tortuosity without neovascularization or macular edema OU. There were also dot-blot hemorrhages in the periphery of the left eye. The patient was informed that he had developed a central retinal vein occlusion (CRVO) in the recent past; he was recommended to control modifiable risk factors and to return if he experienced any changes in vision. Approximately 3 months later, the patient returned, now with worsening vision OU. Measured acuity was 20/30 OD and 20/40 OS. The ophthalmologist obtained images, including color fundus photos and fluorescein angiography of both eyes (Figure 1). The diagnosis of CRVO was still suspected. Because on exam and optical coherence tomography (OCT) there was no macular edema, the patient was again recommended to control blood pressure, body weight, and cholesterol and was recommended to return in a month to check for onset of macular edema (Figure 2).

The patient called 3 weeks later, informing the practice receptionist that his acuity was now much worse OS. The receptionist spoke with the ophthalmologist, who suggested the patient visit a retina specialist immediately. Two days later, the patient was evaluated by a retina specialist.
When further history was obtained, the patient reported having polyarticular arthritis, for which he was taking 400 mg hydroxychloroquine BID and 60 mg of prednisone under the care of a rheumatologist. He recently had a rash that, by the patient’s description, fit a papulosquamous appearance. It involved his thorax and shoulders but had resolved in recent months. There was no palmar rash, skin nodules, or soft tissue growths of concern or recent onset. He also informed the retina specialist that he had a history of unprotected sexual intercourse with multiple male and female partners. At this visit, his measured visual acuity was 20/50 OD and 20/400 OS. Angiography was repeated after finding whitening vessels in the left eye, which demonstrated poor perfusion from an inferior hemiarteriole supplying the macula in addition to interval resolution of some retinal hemorrhages and thinning of the retina on OCT consistent with occlusive vascular disease (Figure 2 and Figure 3). Upon review of the first angiography, it was noted that there was exudation involving the disc and retinal capillaries OU in addition to inner segment/outer segment (IS/OS) disorganization and attenuation with vitreous cell on OCT OU. It was also noted that the first fundus autofluorescence image demonstrated placoid hyperfluorescent deposits throughout both posterior poles (Figure 1).

With this additional history, a preliminary diagnosis of bilateral choroiditis with occlusive retinal vasculitis was made and extensive serum and imaging testing performed. Two days later, rapid plasmin reagin (RPR) and fluorescent treponemal anti-body absorption (FTA-ABS) assays returned positive. The patient was diagnosed with syphilitic uveitis and received 4 million units of aqueous penicillin. The patient also tested positive for HIV. Visual acuity improved to 20/20 OD and 20/80 OS, and hyperfluorescent placoid deposits became far less detectable, but unfortunately occlusive changes to the left macular vasculature remained and the macula continued to appear thin on OCT (Figure 4).

Discussion
In ophthalmology, the term masquerade is believed to have first been used in 1967 when describing a conjunctival carcinoma that had a clinical appearance compatible with chronic conjunctivitis.9 The concept of clinical appearance, imaging, or other testing indicative of a disease which, after more specific and directed testing, may be revealed to be another condition with a similar or identical appearance is not new to medicine in general. Patients who were thought to have diastolic heart failure were later revealed to have hypothyroidism and reversible return of heart function after treatment.10 A patient was diagnosed as having a benign atrial flutter but later testing revealed ventricular tachycardia.11 In the eye, melanoma can be confused for central serous chorioretinopathy12 or an adnexal fungal infection confused for a carcinoma.13 Many patients may be informed that they have age-related macular degeneration when, in fact, retinal pigmentary changes and drusen-like deposits developed due to exposure to pentosan polysulfate sodium (PPS) for interstitial cystitis.14
Syphilitic uveitis due to an infection by Treponema pallidum can produce a constellation of symptoms and exam signs easily confused for other ocular and nonocular diseases. As described in our case example, retinal vein occlusion was mistakenly diagnosed. Patients with secondary and tertiary syphilis may experience diagnostic confusion, even from non-ophthalmic colleagues, when the infection manifests elsewhere.15,16 Within the eye, syphilis has been confused with idiopathic intracranial hypertension,17 pupillary abnormalities,18 progressive outer retinal necrosis,19 and simple spontaneous acute anterior uveitis.20
To ensure an accurate diagnosis, it’s vital to take an extensive history to find any correlations with exam findings or studies. In our patient’s case, his arthritis and his sexual and dermatologic history played an important role in dissuading from RVO. With the addition of more careful assessment of autofluorescence, angiography, and OCT, the diagnosis was suspected.
Worldwide, there are an estimated 12 million new cases of syphilis infection annually, with 90% found in developing countries. Increases in reported cases are seen mostly in men having sexual intercourse with men and those co-infected with HIV.21,22 While uncommon, ocular manifestations are typically associated with neurosyphilis, which may occur at any stage of the disease but manifest roughly 2 to 6 months after infection.23 The most common ocular finding is uveitis, occurring in 2.5% to 5% of patients with tertiary syphilis and can include iritis, chorioretinitis, panuveitis, and placoid choroiditis.24,25
Serologic testing with nontreponemal and treponemal tests is often used in ophthalmic clinical practice. Nontreponemal tests such as RPR and Venereal Disease Research Laboratory (VDRL) can be used for diagnosis and monitoring response to therapy. Treponemal tests such as FTA-ABS or microhemagglutinin assay for T. pallidum (MHA-TP) are more specific. Once these latter tests are positive, the patient generally remains positive for life. Use of either as a single test is insufficient during the patient’s initial encounter and may result in false positives or negatives. With the addition of history and exam, both a treponemal and nontreponemal test are necessary before making a complete diagnosis.
Once a patient has been diagnosed, the clinician is responsible for reporting the case to a state department of health26 and to treat with assistance of an infectious disease specialist. The preferred treatment is with penicillin G for all stages. Sexual partners should be evaluated and treated.27
Conclusion
In summary, a clinician evaluating a patient for a retinal vascular condition should maintain open diagnostic decision patterns. All subtle signs and relevant details should be considered as one approaches the diagnosis, including history, exam results, and ancillary studies. Doing so will ensure that patients like the one described above will receive the most appropriate medical care. NRP
References
1. Centers for Disease Control and Prevention. Hypertension cascade: hypertension prevalence, treatment and control estimates among US adults aged 18 years and older applying the criteria from the American College of Cardiology and American Heart Association’s 2017 Hypertension Guideline—NHANES 2017-2020. May 12, 2023. Accessed January 22, 2024. https://millionhearts.hhs.gov/data-reports/hypertension-prevalence.html
2. National Center for Health Statistics. Multiple cause of death 2018-2021 on CDC WONDER database. Accessed January 22, 2024. https://wonder.cdc.gov/mcd.html
3. Mohamed Q, McIntosh RL, Saw SM, Wong TY. Interventions for central retinal vein occlusion: an evidence-based systematic review. Ophthalmology. 2007;114(3):507-524. doi:10.1016/j.ophtha.2006.11.011
4. Mitchell P, Smith W, Chang A. Prevalence and associations of retinal vein occlusion in Australia: the Blue Mountains Eye Study. Arch Ophthalmol. 1996;114(10):1243-1247. doi:10.1001/archopht.1996.01100140443012
5. The Eye Disease Case-Control Study Group. Risk factors for central retinal vein occlusion. Arch Ophthalmol. 1996;114(5):545-554.
6. Ehlers JP, Fekrat S. Retinal vein occlusion: beyond the acute event. Surv Ophthalmol. 2011;56(4):281-299. doi:10.1016/j.survophthal.2010.11.006
7. Stierman B, Afful J, Carroll MD, et al. National health and nutrition examination survey 2017-March 2020 prepandemic data files—development of files and prevalence estimates for selected health outcomes. National Health Statistics Reports 158. June 14, 2021. Accessed January 22, 2024. https://www.cdc.gov/nchs/data/nhsr/nhsr158-508.pdf
8. Lundeen EA, Burke-Conte Z, Rein DB, et al. Prevalence of diabetic retinopathy in the US in 2021. JAMA Ophthalmol. 2023;141(8):747-754. doi:10.1001/jamaophthalmol.2023.2289
9. Theodore FH. Conjunctival carcinoma masquerading as chronic conjunctivitis. Eye Ear Nose Throat Mon. 1967;46(11):1419-1420.
10. Jamaluddin J, Mohamed Kamel MA, Jamil SN. A masquerade in a symptomatic patient with heart failure. Malays Fam Physician. 2023;18:19. doi:10.51866/tyk.291
11. Nandakumar R, Patel JC, Broadhurst P. Masquerade: a malignant arrhythmia masquerading as benign. Heart. 2004;90(2):e10. doi:10.1136/hrt.2003.024067
12. Macedo SS, Teixeira M, Correia A, Novais A, Cabral C. Ocular melanoma presenting as masquerade syndrome. Eur J Case Rep Intern Med. 2019;6(7):001118. doi:10.12890/2019_001118
13. Mukherjee B, Chatterjee R, Biswas J. Reverse masquerade syndrome: fungal adnexal infection mimicking carcinoma in a HIV-positive patient. Indian J Ophthalmol. 2013;61(9):521-523. doi:10.4103/0301-4738.119454
14. Mukhopadhyay C, Boyce TM, Gehrs KM, et al. Age-related macular degeneration masquerade: a review of pentosan polysulfate maculopathy and implications for clinical practice. Asia Pac J Ophthalmol (Phila). 2022;11(2):100-110. doi:10.1097/APO.0000000000000504
15. Nethers K, Mojica RE, Marks E, et al. A case of secondary syphilis masquerading as cutaneous lymphoma. JAAD Case Rep. 2021;14:17-20. doi:10.1016/j.jdcr.2021.05.036
16. Piraccini BM, Broccoli A, Starace M, et al. Hair and scalp manifestations in secondary syphilis: epidemiology, clinical features, and trichoscopy. Dermatology. 2015;231(2):171-176. doi:10.1159/000431314
17. Rigi M, Almarzouqi SJ, Morgan ML, Lee AG. Papilledema: epidemiology, etiology, and clinical management. Eye Brain. 2015;7:47-57. doi:10.2147/EB.S69174
18. Kiss S, Damico FM, Young LH. Ocular manifestations and treatment of syphilis. Semin Ophthalmol. 2005;20(3):161-167. doi:10.1080/08820530500232092
19. Chao JR, Khurana RN, Fawzi AA, Reddy HS, Rao NA. Syphilis: reemergence of an old adversary. Ophthalmology. 2006;113(11):2074-2079. doi:10.1016/j.ophtha.2006.05.048
20. Yap SC, Tan YL, Chio MT, Teoh SC. Syphilitic uveitis in a Singaporean population. Ocul Immunol Inflamm. 2014;22(1):9-14. doi:10.3109/09273948.2013.829106
21. Puech C, Gennai S, Pavese P, et al. Ocular manifestations of syphilis: recent cases over a 2.5-year period. Graefes Arch Clin Exp Ophthalmol. 2010;248(11):1623-1629. doi:10.1007/s00417-010-1481-z
22. Centers for Disease Control and Prevention. Sexually transmitted disease surveillance, 2009. November 2010. Accessed January 22, 2024. https://www.cdc.gov/std/stats/archive/surv2009-Complete.pdf
23. Durnian JM, Naylor G, Saeed AM. Ocular syphilis: the return of an old acquaintance. Eye (Lond). 2004;18(4):440-442. doi:10.1038/sj.eye.6700687
24. Aldave AJ, King JA, Cunningham ET Jr. Ocular syphilis. Curr Opin Ophthalmol. 2001;12(6):433-441. doi:10.1097/00055735-200112000-00008
25. Gass JD, Braunstein RA, Chenoweth RG. Acute syphilitic posterior placoid chorioretinitis. Ophthalmology. 1990;97(10):1288-1297. doi:10.1016/s0161-6420(90)32418-1
26. Chorba TL, Berkelman RL, Safford SK, Gibbs NP, Hull HF. Mandatory reporting of infectious diseases by clinicians. JAMA. 1989;262(21):3018-3026.
27. Workowski KA, Berman S; Centers for Disease Control and Prevention (CDC). Sexually transmitted diseases treatment guidelines, 2010 [published correction appears in MMWR Recomm Rep. 2011 Jan 14;60(1):18. Dosage error in article text]. MMWR Recomm Rep. 2010;59(RR-12):1-110.









